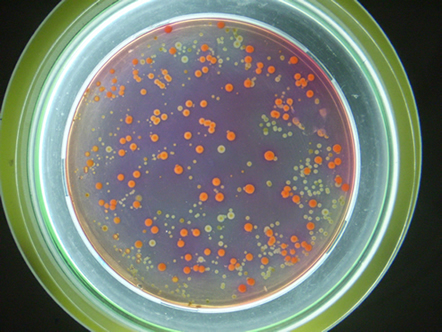

Research Interests
I am a Nature fan since I was a child. I was fascinated (and still I am) in animals and their behaviors, why plants grow where they do or in communities of marine invertebrates in the rocky coast around my small town. This enthusiastic attitude resulted in a Bachelor and a PhD in biology. During my dissertation, I dived in a special host-parasite system: bacterial community on bird eggshells and their relationship with avian life history traits. I am still working in this really interesting research line extending their limits to other bacterial community as in the skin of vertebrates, in the geographical variation of bacterial communities and egg defenses or the role of egg coloration in bacterial assemblages. This research line have pushed me to develop an interdisciplinary formation, a good network of collaborators and have woke up new avenues for my research. I am also interested in other topics as migration patterns and behavior, bacterial community ecology or other host-parasite interactions.
In other words:
Bacteria-Vertebrate interactions
- The role of bacterial community on life history traits and fitness of birds
- Bacteria on the vertebrate skin
- Geographical variation in gut microbiota in birds
- Influence of diet in gut bacteria and vertebrate behavior
Migration patterns and behavior
- Swallows in South Spain
- Climate changes and migration timing
- Route changes in white storks
Host-parasite Interactions
Bacterial community ecology
|
 |
Collaborators
Juan Soler, my PhD advisor
Manuel Martinez Bueno, my other PhD advisor
Manuel Martín-Vivaldi, the responsible researcher in the hoopoe-bacteria system where I have been collaborating so extensively.
Rob Knight, the amazing PI that opened the doors of his lab for my first Postdoc
Anders P. Møller, the fountain of scientific ideas whom taught me so many things during my PhD stays.
Institutions
EEZA (where I worked in my PhD)
Department of Zoology - University of Granada (where I defended my PhD dissertation and I have been working for some years)
Department of Microbiology - University of Granada
(where I have performed and still do my lab work)
COCN (a non-profitable organization where I have been collaborating for several years)
Publications
Peer-reviewed Articles
31 |
Bacterial density rather than diversity correlates with hatching success across different avian species
Peralta-Sánchez JM, Martín-Platero AM, Wegener-Parfrey L, Martínez-Bueno M, Rodríguez-Ruano S, Navas-Molina JA, Vázquez-Baeza Y, Martín-Gálvez D, Martín-Vivaldi M, Ibáñez-Álamo JD, Knight R, Soler JJ (2018)
FEMS Microbiology Ecology 94(3)
| |
 |
|
|
30 |
Ectoparasite activity during incubation increases microbial growth on avian eggs
Tomás G, Martín-Gálvez D, Ruiz-Castellano C, Ruiz-Rodriguez M, Peralta-Sánchez JM, Martín-Vivaldi M, Soler JJ (2018)
Microbial Ecology. doi: 10.1093/femsec/fiy022
| |
 |
|
|
29 |
A communal catalogue reveals Earth's multiscale microbial diversity
Thompson LR, Sanders JG, McDonald D, Amir A, Ladau J, Locey KJ, Prill RJ, Tripathi A, Gibbons SM, Ackermann G, Navas-Molina JA, Janssen S, Kopylova E, et al. (2017)
Nature 551(7681), 457-463
| |
Link
|
|
28 |
Nestedness of hoopoes bacterial communities: symbionts from the uropygial gland to the eggshell
Soler JJ, Martínez-García A, Rodríguez-Ruano SM, Martínez-Bueno M, Martín Platero AM, Peralta-Sánchez JM, Martín-Vivaldi M (2016)
Biological Journal of the Linnean Society 118, 763-773
| |
 |
|
|
27 |
The microbiome of the uropygial secretion in hoopoes is shaped along the nesting phase
Martínez-García A, Martín-Vivaldi M, Ruiz-Rodríguez MM, Martínez-Bueno M, Arco L, Rodríguez-Ruano SM, Peralta-Sánchez JM, Soler JJ (2016)
Microbial Ecology 72, 1 - 10
| |
 |
|
|
26 |
Nest bacterial environment affects microbiome of hoopoe eggshells, but not that of the uropygial secretion
Martínez-García A, Martín-Vivaldi M, Rodríguez-Ruano SM, Peralta-Sánchez JM, Valdivia E, Soler JJ (2016)
PLoS ONE 11, e0158158
| |
 |
|
|
25 |
The hoopoe's uropygial gland hosts a bacterial community influenced by the living conditions of the bird
Rodríguez-Ruano SM, Martín-Vivaldi M, Martín-Platero AM, López-López JP, Peralta-Sánchez JM, Ruiz-Rodríguez MM, Soler JJ, Valdivia E, Martínez-Bueno, M (2015)
PLoS ONE 10, e0139734
| |
 |
|
|
24 |
Laying date, incubation and egg breakage as determinants of bacterial load on bird eggshells: experimental evidence
Soler JJ, Ruiz-Rodríguez MM, Martín-Vivaldi M, Peralta-Sánchez JM, Ruiz-Castellano C, Tomás G (2015)
Oecologia 179, 63 74
| |
 |
|
|
23 |
Eggshell bacterial load is related to antimicrobial properties of feathers lining barn swallow nests
Peralta-Sánchez JM, Soler JJ, Martín-Platero AM, Knight R, Martínez-Bueno M, Møller AP (2014)
Microbial Ecology 67, 480 - 487
| |
 |
|
|
22 |
Eggshell pigmentation has no evident effects on offspring viability in common kestrels
Fargallo JA, López-Rull I, Miksík I, Eckhardt A, Peralta-Sánchez JM (2014)
Evolutionary Ecology 28, 627 - 637
| |
 |
|
|
21 |
Environmental factors shape the community of symbionts in hoopoe uropygial gland more than genetic factors
Ruíz-Rodríguez MM, Soler JJ, Martín-Vivaldi M, Martín-Platero AM, Méndez M, Peralta-Sánchez JM, Ananou S, Valdivia E, Martínez-Bueno M (2014)
Applied and Environmental Microbiology 80, 6714 - 6723
| |
 |
|
|
20 |
Hoopoes color their eggs with antimicrobial uropygial secretions
Soler JJ, Martín-Vivaldi M, Peralta-Sánchez JM, Arco L, Juarez-García N (2014)
Naturwissenschaften 101, 697 - 705
| |
 |
|
|
19 |
Mirror-mark tests performed on jackdaws reveal potential methodological problems in the use of stickers in avian mark-test studies
Soler M, Pérez-Contreras T, Peralta-Sánchez JM (2014)
PLoS ONE 9(1), e86193
| |
 |
|
|
18 |
Special structures of hoopoe eggshells enhance the adhesion of symbiont-carrying uropygial secretion that increase hatching success
Martín-Vivaldi M, Soler JJ, Peralta-Sánchez JM, Arco L, Martín-Platero AM, Martínez-Bueno M, Ruíz-Rodríguez MM, Valdivia E (2014)
Journal of Animal Ecology 83, 1289 - 1301
| |
 |
|
|
17 |
Advancing our understanding of the human microbiome using QIIME
Navas-Molina JA, Peralta-Sánchez JM, González A, Mcmurdie PJ, Vázquez-Baeza Y, Xu Z, Ursell LK, Lauber C, Zhou H, Song SJ, Huntley J, Ackermann GL, Berg-Lyons D, Holmes S, Caporaso JG, Knight R (2013)
Methods in Enzimology 531, 371 - 444
| |
 |
|
|
16 |
Antimicrobial activity and genetic profile of enteroccoci isolated from hoopoes uropygial gland
Ruíz-Rodríguez MM, Valdivia E, Martín-Vivaldi M, Martín-Platero AM, Martínez-Bueno M, Méndez M, Peralta-Sánchez JM, Soler JJ (2012)
PLoS ONE 7(7), e41843
| |
 |
|
|
15 |
Avian life history traits influence eggshell bacterial loads: a comparative analysis
Peralta-Sánchez JM, Martín-Vivaldi M, Martín-Platero AM, Martínez-Bueno M, Oñate-Guiterrez M, Ruíz-Rodríguez MM, Soler JJ (2012)
Ibis 154, 725 - 737
| |
 |
|
|
14 |
Cognitive skills and bacterial load: comparative evidence of costs of cognitive proficiency in birds
Soler JJ, Peralta-Sánchez JM, Martín-Vivaldi M, Martín-Platero AM, Flensted-Jensen E, Møller AP (2012)
Naturwissenschaften 99, 111 -122
| |
 |
|
|
13 |
Goshawk prey have more bacteria than non-prey
Møller AP, Peralta-Sánchez JM, Nielsen JT, López-Hernández E, Soler JJ (2012)
Journal of Animal Ecology 81, 403 - 410
| |
 |
|
|
12 |
The evolution of size of the uropygial gland: mutualistic feather mites and uropygial secretion reduce bacterial loads of eggshells and hatching failures of european birds
Soler JJ, Peralta-Sánchez JM, Martín-Platero AM, Martín-Vivaldi M, Martínez-Bueno M, Møller AP (2012)
Journal of Evolutionary Biology 25, 1779 -1791
| |
 |
|
|
11 |
Brood parasitism is associated with increased bacterial contamination of host eggs: bacterial loads of host and parasitic eggs
Soler JJ, Peralta-Sánchez JM, Martínez-Bueno M, Martín-Vivaldi M, Martín Gálvez D, Vela AI, Briones V, Pérez-Contreras T (2011)
Biological Journal of the Linnean Society 103, 836 - 848
| |
 |
|
|
10 |
Colour composition of nest lining feathers affects hatching success of barn swallows, Hirundo rustica (Passeriformes: Hirundinidae)
Peralta-Sánchez JM, Møller AP, Soler JJ (2011)
Biological Journal of the Linnean Societ 102, 67 - 74
| |
 |
|
|
9 |
DNA sampling from eggshell swabbing is widely applicable for wild bird populations as demonstrated in 23 species
Martín-Gálvez D, Peralta-Sánchez JM, Dawson D, Martín-Platero AM, Martínez-Bueno M, Burke T, Soler JJ (2011)
Molecular Ecology Resources 11, 481 - 493
| |
 |
|
|
8 |
Innate humoural immunity is related to eggshell bacterial load of european birds: a comparative analysis
Soler JJ, Peralta-Sánchez JM, Flensted-Jensen E, Martín-Platero AM, Møller AP (2011)
Naturwissenschaften 98, 807 - 813
| |
 |
|
|
7 |
Migratory divides and their consequences for dispersal, population size and parasite-host interactions
Møller AP, Garamszegi, LZ, Peralta-Sánchez JM, Soler JJ (2011)
Journal of Evolutionary Biology 24, 1744 - 1755
| |
 |
|
|
6 |
Antibiotic-producing bacteria as a possible defence of birds against pathogenic microorganisms
Soler JJ, Martín-Vivaldi M, Peralta-Sánchez JM, Ruíz-Rodríguez MM (2010)
Open Ornithology 3, 93 - 100
| |
 |
|
|
5 |
Antimicrobial chemicals in hoopoe preen secretions are produced by symbiotic bacteria
Martín-Vivaldi M, Peña A, Peralta-Sánchez JM, Sánchez-Moreno L, Ananou S, Ruíz-Rodríguez MM, Soler JJ (2010)
Proceedings of the Royal Society B: Biological Sciences 277 123 - 130
| |
 |
|
|
4 |
Chelex-based DNA isolation procedure for the identification of microbial communities of eggshell surfaces
Martín-Platero AM, Peralta-Sánchez JM, Soler JJ, Martínez-Bueno M (2010)
Analytical Biochemistry 39, 253 - 255
| |
 |
|
|
3 |
Number and colour composition of nest lining feathers predict eggshell bacterial community in barn swallow nests: an experimental study
Peralta-Sánchez JM, Møller AP, Martín-Platero AM, Soler JJ (2010)
Functional Ecology 24, 426-433
| |
 |
|
|
2 |
Seasonal, sexual and developmental differences in hoopoe Upupa epops preen gland morphology and secretions: evidence for a role of bacteria
Martín-Vivaldi M, Ruíz-Rodríguez MM, Soler JJ, Peralta-Sánchez JM, Mendez M, Valdivia E, Martín-Platero AM, Martínez-Bueno M (2009)
Journal of Avian Biology 40, 191 - 205
| |
 |
|
|
1 |
Symbiotic association between hoopoes and antibiotic-producing bacteria that live in their uropygial gland
Soler JJ, Martín-Vivaldi M, Ruíz-Rodríguez MM, Valdivia E, Martín-Platero AM, Martínez-Bueno M, Peralta-Sánchez JM, Mendez M (2008)
Functional Ecology 22, 864 - 871
| |
 |
|
|
|